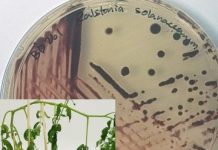
Research: Early detection of disease resistance in food crops —

Research: A PLOS Neglected Tropical Diseases press release —
Bartonella are bacteria that cause endocarditis, a potentially life-threatening illness in humans and domestic animals. In Latin America, common vampire bats (Desmodus rotundus)...
Research: South Africa’s new jurassic giant —
A new species of a giant dinosaur has been found in South Africa's Free State Province. The plant-eating dinosaur, named Ledumahadi mafube, weighed...
Research: Including effects of waves and erosion expands vulnerable areas —
By including models of dynamical physical processes such as erosion and wave run-up, a team of researchers from the University of Hawai'i at...
Research: Following the path of chemicals through the soil
A new and quick way to predict the transport of chemicals through the soil has been developed.
Research: Local citizen scientists help biologists detect and track Alaska’s marine invaders —
Alaska has a near-pristine marine ecosystem -- it has fewer invasive species in its waters than almost any other state in the U.S....
Research: How swarms of nanomachines could improve the efficiency of any machine —
All machines convert one form of energy into another form - for example a car engine turns the energy stored in fuel into...
Research: PCB pollution threatens to wipe out killer whales —
More than forty years after the first initiatives were taken to ban the use of PCBs, the chemical pollutants remain a deadly threat...
Research: Early detection of disease resistance in food crops —
Bacterial wilt devastates food crops all over the world. It destroys major crop plants such as tomatoes, potatoes, bananas, ginger and pepper. It...
Research: A protein prevents plants from premature flowering —
The induction of flowering is of major importance from an ecological and agronomic point of view. Timely and synchronous flowering is essential to...
Research: Silver fox study reveals genetic clues to social behavior —
In 1959, Russian scientists began an experiment to breed a population of silver foxes, selecting and breeding foxes that exhibited friendliness toward people....
Top News
Hey ISIS, You Suck: Local Muslims Post Anti-ISIS Billboard
A new billboard on Manchester Road in Missouri reads, "HEY ISIS, YOU SUCK!!! From: #ActualMuslims."
A group of Muslim-Americans have put up a blunt billboard...